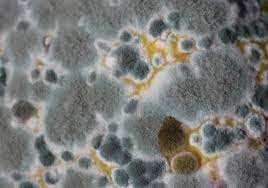

切爾諾貝利核泄露事件
這個事故是發(fā)生在上世紀(jì)八十年代于烏克蘭的切爾諾貝利的一起核反應(yīng)堆破裂事故,也是歷史上最嚴(yán)重的核泄露事故。事故主要原因是由于操作人員技術(shù)的不嫻熟和訓(xùn)練不到位造成的,導(dǎo)致反應(yīng)堆在進(jìn)行緊急停機(jī)后的供電測試時,功率急劇增加,才使反應(yīng)堆的破裂。該事故后來對蘇聯(lián)的影響特別大,另外,此次事故對當(dāng)?shù)厣踔寥澜绲暮芏喾矫娑荚斐闪穗y以想象的惡劣影響,僅僅事件所造成的死亡人數(shù)就因太多復(fù)雜的原因無法計算。

當(dāng)時在事件發(fā)生不久后,當(dāng)?shù)鼐椭苯咏贯t(yī)生們在死亡證明上提任何關(guān)于放射死的死因。后來在世衛(wèi)組織所提出的切爾諾貝利事件報告中,是這樣說的,這次事件造成了56人死亡,其中包括47名救災(zāi)人員和9名患甲狀腺癌的兒童,但是后來估算了被高度輻射物質(zhì)深度影響的人有60余萬,這就意味著之后將有至少4000人死于癌癥。這次事故讓切爾諾貝利這座城市瞬間變成了無人居住的荒廢之地。

以核輻射為食的黑色真菌
事發(fā)5年后,盡管輻射非常危險,但還是需要不停地做調(diào)查工作,于是科研組派出了機(jī)器人去調(diào)查科研。機(jī)器人剛開始調(diào)查的時候,科研人員就發(fā)現(xiàn)了每次在淺色的墻壁上總是黑乎乎的,起初并沒有在意,后來近距離觀察了這個現(xiàn)象,居然驚人地發(fā)現(xiàn)這是一種真菌。

核反應(yīng)堆破裂后居然還有生物生存下來?這確實(shí)是一件不可思議的事情,畢竟如此高的輻射環(huán)境居然有生物可以生存下來,確實(shí)讓人大吃一驚,然而更神奇的事情還在后面。后來又在冷卻水等核輻射含量很高的地方發(fā)現(xiàn)了它們,經(jīng)研究后居然得出了這樣一個結(jié)論,它們不是短暫的依存,而是在核反應(yīng)堆中繁殖,并且以核輻射為食。

后來在美國一所名為阿爾伯特的醫(yī)學(xué)院揭開了這種真菌的奧秘,他們認(rèn)為這與真菌內(nèi)的黑色素有關(guān)。說到黑色素,這與我們的膚色和頭發(fā)顏色是密切相關(guān)的,但是在這種真菌體內(nèi)發(fā)揮了特殊的神奇作用。

生物學(xué)家們推測,它們可能利用黑色素將放射性物質(zhì)轉(zhuǎn)化為自己的食物,并能夠更好地刺激自己發(fā)育成長,就像綠植利用葉綠素進(jìn)行光合作用一樣。后來也證實(shí)了事實(shí)的確如此,它們果真把伽馬射線轉(zhuǎn)化為了自身的營養(yǎng)物質(zhì)。所以現(xiàn)在科學(xué)界普遍認(rèn)為它們身上的特殊黑色素可以抵御放射性的穿透,甚至將其轉(zhuǎn)化為化學(xué)能。
這種真菌能否加以利用造福人類?
這種被命名為新型隱球菌的真菌,有可能讓人類避免遭受致命的射線傷害。要知道,新型隱球菌被列為危險的真菌之一,抵抗力薄弱的人或免疫系統(tǒng)受損的人,被新型隱球菌感染的話,很可能造成生命危險,這種主要感染呼吸道的疾病被稱為隱球菌病,在肺中形成小結(jié)瘤,若進(jìn)入血液會導(dǎo)致其他更嚴(yán)重的并發(fā)癥。那這種真菌到底可以用來保護(hù)人類嗎?

首先,防輻射對宇航員的工作是必不可少的,如果這種真菌或黑色素用于新型宇航服的生產(chǎn),那效果應(yīng)該是不錯的,目前,NASA正在研究能否從新型隱球菌中提取黑色素,將其制作為太空用的防曬霜的成分。就在去年,已有科研人員將源于這種真菌上的黑色素送往國際太空站進(jìn)行實(shí)驗(yàn)。

其次,它們還能幫助接受輻射治療的癌癥患者、核電站的工作人員或飛行員們,防止他們在操作時吸收致命劑量的射線。而且新型隱球菌還能被作為輻射轉(zhuǎn)換能量的工具,進(jìn)而成為一種可再生能源。
那些能夠在核輻射下生存并生長的生物確實(shí)讓人大開眼界,也許除了這種真菌還存在更多不可思議的生物,不僅會促進(jìn)科學(xué)的進(jìn)一步發(fā)展,而且對人文明的進(jìn)步也起到重要的作用。
應(yīng)急通訊——我們從福島事件中學(xué)到了什么?
廣西順利完成海域輻射環(huán)境預(yù)警監(jiān)測自動采樣設(shè)備投放